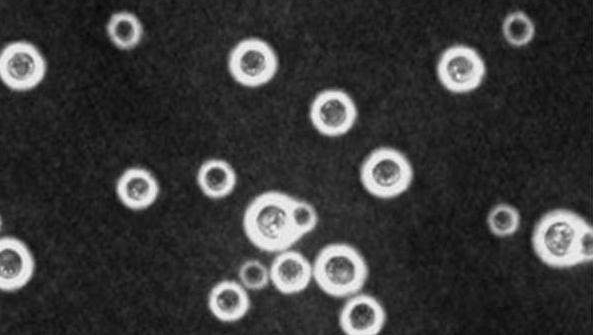
男子离家三个月后，一进屋子瞬间傻眼了，每个家庭都要小心防范！

导读:有些人為了摆脱日常生活上的庞大压力,总会排个假期让自己到外头度假散散心,因为能出去看看是每个人的梦想!不过当你离开后却忘记关好门窗可是会后悔莫及的... 在Redditor上的一...
有些人為了摆脱日常生活上的庞大压力,总会排个假期让自己到外头度假散散心,因为能出去看看是每个人的梦想!不过当你离开后却忘记关好门窗可是会后悔莫及的...

在Redditor上的一位用户,上网PO出了自己忘记关门窗的后果!看了下面的这些图131mm美女图片网(www.131mm.cc)的编辑小珊宁愿家中被盗也不要发生这样的场景...

这间屋子只因為屋主忘了关好门窗,三个月后鸽子大军进驻了! 看到这张图,屋主可能要崩溃了...这到底要清多久?

鸽子甚至在屋里头养育下一代...
虽然整个屋子非常脏乱,但至少他们有试着用厕所... 鸽子及其他鸟类粪便经调查后发现有隐球菌,而隐球菌症是由隐球菌所引起的一种亚急性或慢性酵母菌型真菌感染。当人们吸入被隐球菌污染的尘埃,或是经由伤口或饮食可以间接感染,一旦受感染可能无症状或出现肺炎、胸水及其他更严重的表现。肺部感染是常见的病症,中枢神经系统的感染通常呈亚急性或慢性病程,症状為发烧、头痛、恶心、呕吐等,也可能出现视力丧失、顏面瘫痪。
面对这些庞大的鸽粪最好要妥善处理!必须使用消毒水消毒或集中焚烧,减少病菌传播。若家中有人皮肤有伤口时,须包扎以免接触而感染。倘若家里有高危险群患者包括糖尿病、红班性狼疮、T 淋巴球缺陷疾病、白血病、爱滋病等免疫缺陷或抵抗力差者,应避免接触鸟及污染之土壤、鸽粪、带菌的食物。 没想到只是忘记关好门窗却发生这样的惨事,看来这位网友日后出远门一定会多加巡视家里!避免不必要的生物再次进驻。